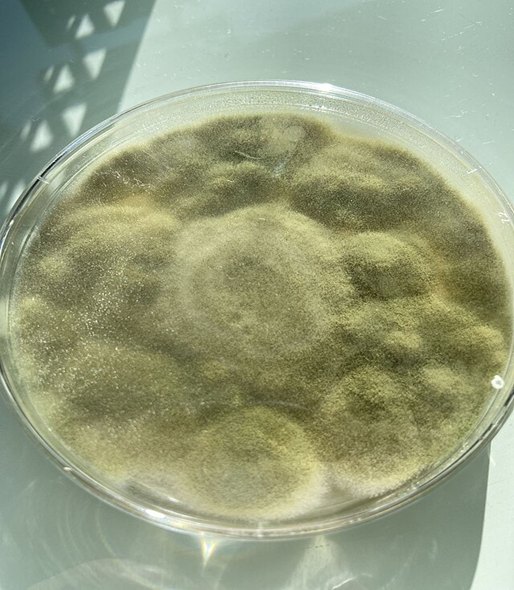

From a ‘Pharaoh's Curse’ to a ‘Pharaoh's Cure’!! Could a Fungus Found in an Ancient Egyptian Tomb Help Treat Breast Cancer?
Cancer is one of the world’s biggest health challenges, causing nearly 10 million deaths in 2020, which is about one in every six people [1]. This number is expected to rise to over 13 million by 2030 [1]. But why is this?
Subscribe to the Bare Science newsletter and follow us on our social media pages to stay updated with the latest articles, including an answer to this troubling question. Become a member to gain early access to all articles and other exclusive perks.
Challenges
Each cancer case is unique, shaped by differences in its origin, genetic mutations, and other factors. These details help doctors classify, diagnose, and treat different cancers. However, research suggests that a new natural treatment for cancer may be available[1].
To explore this further, we will look at the findings from the scientific paper “Cytotoxic Potential of Bioactive Compounds from Aspergillus flavus, an Endophytic Fungus Isolated from Cynodon dactylon, against Breast Cancer: Experimental and Computational Approach” [1].
Breast cancer is one of the most common cancers in women, with around 1.38 million new cases diagnosed each year [1]. Due to advances in medicine, early breast cancer can often be cured. Standard treatments often include surgery, radiation, and chemotherapy; however, newer approaches also incorporate targeted drugs and immunotherapies [1]. Some examples are
· Chemotherapy drugs like paclitaxel and doxorubicin [1].
· Targeted drugs like lapatinib and neratinib [1].
· Monoclonal antibodies such as trastuzumab (Herceptin) [1].
However, many breast cancers eventually become resistant to treatment [1]. Additionally, the side effects from existing therapies can greatly affect patients' quality of life [1]. For this reason, scientists are exploring new compounds that kill cancer cells more selectively with fewer side effects [1]. Scientists are aiming to target a protein called Bcl-2, which helps cancer cells avoid dying and resist treatment [1].
Natural Medicine
Natural products from plants, fungi, bacteria, and algae produce many compounds that can fight cancer [1]. Fungi are especially interesting because there are millions of species, but only a tiny fraction have been studied [1].
Among these is a special kind of fungi called endophytic fungi (they live inside plants without harming them) [1]. These fungi produce useful substances, including antioxidants and cancer-fighting compounds, but most of these compounds remain unexplored [1].
Focus on Bermuda Grass and Its Fungi
Bermuda grass (scientific name Cynodon dactylon) is important in traditional medicine in various cultures [1]. The plant has been shown to have many anti-cancer effects in studies, and this is because it hosts many endophytic fungi [1].
Researchers collected a fungus, identified as Aspergillus flavus, which showed strong antioxidant activity and was studied further [1]. This fungus was shown to be effective in reducing liver cancer in mice [1].
Pharaoh’s Curse to a Pharaoh’s Cure
Aspergillus flavus is the same fungus discovered in ancient tombs like that of Egypt’s King Tutankhamun, where its toxic spores were blamed for the mysterious deaths of archaeologists, often linked to the so-called ‘pharaoh's curse.’ However, could this curse become a cure?

Can this Fungus Kill Cancer?
Testing Anticancer Properties
The extract from this fungus was tested on human breast cancer cells. Key findings include:
· The extract effectively killed cancer cells [1].
· The extract caused cancer cells to die through programmed cell death (apoptosis) [1]. Apoptosis is a natural process where damaged or unneeded cells self-destruct in an orderly way to keep the body healthy.
· 53% of the targeted cancer cells showed signs of dying [1].
· The fungus extract disrupted the cells’ energy centres (mitochondria) and caused damage to their nuclei [1]. This is an early sign of cell death [1].
· It also increases harmful molecules called reactive oxygen species (ROS), which help kill cancer cells [1].
The Importance of These Findings
This study suggests that A. flavus produces natural compounds that may kill breast cancer cells, especially those resistant to current therapies [1]. This makes it a promising natural source of anticancer agents [1].
Aspergillus flavus increases harmful molecules inside breast cancer cells and blocks their survival proteins, thus causing these cells to die [1].
Groundbreaking Research for Natural Treatment
This research provides evidence that Aspergillus flavus, a fungus from Bermuda grass, might provide a new, natural anti-cancer drug [1]. It provides the framework for future drug developments; however, more research is needed to test the fungus's safety and see how truly effective it is in animals and humans [1].
Nevertheless, it provides a bit of hope that there are still new and innovative solutions for cancer and other medical diseases and conditions that are waiting to be discovered and tested.
If you want to stay informed about our latest articles, make sure to subscribe to the Bare Science newsletter. Become a member to receive early access and other exclusive perks.
References